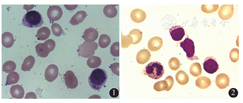

探讨T细胞大颗粒淋巴细胞白血病(T-LGLL)合并格林-巴利综合征(GBS)的临床特征及诊治方法。
回顾性分析河南省肿瘤医院诊治的1例T-LGLL合并GBS患者临床资料,并进行文献复习。
患者,男性,66岁,淋巴细胞增高15年未行特殊治疗,确诊T-LGLL后,予环孢素A(CsA)+甲氨蝶呤(MTX)方案化疗,化疗中患者红细胞计数降低,减量CsA同时给予泼尼松治疗,后因患者不耐受,调整为环磷酰胺(CTX)+MTX方案化疗。化疗期间患者出现肠道和肺部感染,后出现肌力下降、发音含糊不清、吞咽困难等症状。查体双侧肢体肌力Ⅳ级,肌张力低,腱反射未引出。脑脊液:总蛋白1.187 g/L;无色、透明、无凝块;Pandy实验阴性;白细胞计数0×109/L;结合临床表现及脑脊液蛋白-细胞分离现象确诊GBS,给予大剂量丙种球蛋白治疗,症状逐渐好转。出院后口服CsA+CTX治疗1年,血象稳定,神经系统恢复正常。
T-LGLL合并GBS罕见,发病可能与T-LGLL患者淋巴细胞功能紊乱以及化疗后免疫抑制合并感染有关。治疗除对原发病及感染控制外,针对GBS的静脉输注免疫球蛋白等治疗也非常必要。

版权归中华医学会所有。
未经授权,不得转载、摘编本刊文章,不得使用本刊的版式设计。
除非特别声明,本刊刊出的所有文章不代表中华医学会和本刊编委会的观点。
T细胞大颗粒淋巴细胞白血病(T-LGLL)是一类罕见的淋巴增殖性疾病,其特征为CD3+ CD8+细胞毒性T细胞(CTL)克隆性增殖,常合并自身免疫疾病[1]。格林-巴利综合征(GBS)是一种常见的脊神经和周围神经脱髓鞘改变的神经系统自身免疫性疾病[2]。T-LGLL合并GBS非常罕见,现对我院诊治的1例T-LGLL合并GBS患者的临床资料进行分析,并复习国内外相关文献,探讨两种疾病的发病关系及诊治特点。
患者,男性,66岁。因发现淋巴细胞增高15年余,于2015年4月入我院。患者15年余前受凉后出现寒战、高热,血常规检查发现淋巴细胞数增高,未行特殊治疗。5年余前无明显诱因出现乏力,伴气促,于我院检查发现贫血,淋巴细胞数仍高,白细胞计数(WBC)14.97×109/L,血红蛋白(Hb)53 g/L,淋巴细胞比例0.92;行骨髓穿刺,流式细胞术免疫分型分析:异常细胞群约占81.2%,cCD3、CD3、CD8、CD7、CD38、HLA-DR均阳性表达,结合细胞学检查诊断为T淋巴细胞增殖性疾病,给予输血6 U,好转出院,未行进一步治疗。2015年4月因再次无明显诱因出现乏力而入我院。入院查体:贫血貌,全身皮肤黏膜无出血点,浅表淋巴结未触及肿大,眼睑结膜苍白。胸骨叩击痛,双肺呼吸音清,心率80次/min,心律齐,腹软,肝脾肋缘下未触及。双下肢无水肿。血常规示:WBC 3.54×109/L,红细胞计数(RBC)1.28×1012/L,Hb 46 g/L,血小板计数(Plt)41×109/L,淋巴细胞比例0.82。骨髓象示:骨髓有核细胞增生减低,成熟红细胞大小不一,部分红细胞充盈欠佳;淋巴细胞比例明显增高(0.84),其中68%的淋巴细胞胞质内可见较多大小不一嗜天青颗粒,单核细胞形态大致正常(图1)。外周血WBC稍减低,淋巴细胞比例明显增高(0.90),其中79%的淋巴细胞胞质内可见较多大小不一嗜天青颗粒(图2)。


流式细胞术免疫分型:异常T细胞表型;R3门为异常T细胞,约占有核细胞的81.8%,表达CD2、CD7、CD3、CD8、CD45RA,弱表达CD45RO,部分表达CD57、CD56,不表达CD16、CD5、CD4、CD25、CD26、TCRγδ,符合T-LPD表型,倾向大颗粒细胞白血病;大颗粒淋巴细胞免疫表型检查:成熟淋巴细胞群占有核细胞的76.5%;CD3- CD16+/CD56+ NK细胞占淋巴细胞的0.22%;CD3+ CD16+/56+ NK样T细胞占淋巴细胞的57.8%;CD3+ CD57+ LGL细胞占淋巴细胞的37.9%;T细胞受体(TCR)基因重排检测,发现TCRG区出现单克隆基因重排。诊断为T-LGLL。于2015年4月25日给予环孢素A(CsA)+甲氨蝶呤(MTX)方案化疗(MTX 17.5 g 1次/周,CsA 125 mg 1次/12 h口服),并输注血制品等对症支持治疗。患者血象较前改善。期间出现胃部不适及肾功能损害,考虑CsA所致,给予减量CsA,同时给予泼尼松30 mg 1次/d。治疗期间患者血象较稳定,但因对CsA不耐受,调整方案为环磷酰胺(CTX)+MTX方案(CTX 50 mg 1次/d,MTX剂量同前),同时逐步减量CsA及泼尼松。其间患者因不洁饮食后合并肠道感染,根据药敏结果应用亚胺培南西司他汀应用治疗,但血象持续下降,持续发热,肺部CT提示感染,GM试验阳性,考虑肺部真菌感染,行抗感染治疗。2015年8月6日患者出现双下肢肌力下降,并逐渐加重,渐出现四肢乏力,无力行走,双上肢尚可抬起,精神萎靡,神情淡漠,发音含糊不清,吞咽困难。检查双侧瞳孔约3 mm,对光反射灵敏,双侧鼓腮、示齿差,双侧肢体肌力Ⅳ级,肌张力低,腱反射未引出,感觉正常,病理反射阴性。血常规:WBC 2.83×109/L,RBC 2.48×1012/L,Hb 73 g/L,Plt 51×109/L,中性粒细胞比例0.81,淋巴细胞比例0.16。头颅CT未见异常。脑部磁共振成像(MRI)提示副鼻窦炎、双侧乳突炎,脑实质MRI平扫未见明显异常。行脑脊液流式细胞术检测,共获取有核细胞数1 584个,未见异常淋巴细胞。脑脊液生化检测:葡萄糖5.87 mmol/L,Cl- 117.9 mmol/L,总蛋白1.187 g/L;无色、透明、无凝块,Pandy实验阴性,WBC 0×109/L;脑脊液细胞学检查未见异常。结合临床表现及蛋白-细胞分离现象诊断为GSB。于2015年8月7日起给予大剂量丙种球蛋白(400 mg/kg,1次/d,静脉滴注,连续5 d),治疗后肌力较前稍恢复。后患者出院,持续口服CsA+CTX 1年,随访至截稿前,患者血象基本稳定,四肢肌力恢复,发音清晰,正常进食,大小便正常。
LGLL是一组以胞质中含嗜苯胺蓝颗粒的淋巴细胞克隆性增殖为特征的疾病,其肿瘤细胞起源于CD3+ CTL和CD3- NK细胞,属于成熟T/NK细胞肿瘤范畴。根据其不同起源分为T细胞性和NK细胞性,并根据其临床特点分为惰性和侵袭性,分别命名为惰性T-LGLL、侵袭性T-LGLL、慢性NK细胞白血病(惰性)及侵袭性NK细胞白血病。惰性T-LGLL约占所有LGLL的85%,患者中位生存期10年以上,中位诊断年龄约60岁,发病无性别差异。约1/3患者在疾病诊断时无症状,多因其他原因发现血象异常而诊断。主要诊断标准:(1)外周血T-LGL持续增多,淋巴细胞总数常在2×109/L~20×109/L,亦有25%~30%的T-LGLL患者外周血T-LGL为0.5×109/L;(2)具备特征性的免疫表型,即CD3+、CD8+、CD57+、CD4-、CD56-,用聚合酶链反应或蛋白印迹法检测TCR基因重排可以明确LGL的单克隆性,一般为TCRαβ+,少数患者为变异亚型,如CD3+ CD4+ CD8- CD57+ TCRαβ+或CD3+ CD4+ CD8+ CD57+ TCRαβ+或CD3+ CD4- CD8- CD57+ TCRγδ+[1];(3)有外周血细胞减少、脾大等临床表现,多伴有类风湿性关节炎、纯红再生障碍性贫血(AA)等自身免疫性疾病[1],对没有临床症状且外周血LGL<0.5×109/L的患者,需要行骨髓检查,骨髓中克隆性大颗粒淋巴细胞浸润支持LGLL的诊断。
T-LGLL的一线治疗以免疫抑制为主。小剂量MTX(每周10 mg/m2)可有效诱导缓解,CTX 50~100 mg/d或CsA每日5~10 mg/kg是MTX的有效替代方案[3]。改变治疗方案之前应至少原方案维持治疗4周以上。目前公认这些治疗方案是基于免疫调节机制而非针对T-LGLL的细胞毒效应起作用[4]。尽管CsA是首选,但据观察CsA的不良反应较小剂量MTX和CTX严重,尤其是对于老年人。在使用CsA治疗使中性粒细胞恢复正常或获得最佳疗效后,应降低使用剂量,采用最小有效剂量维持治疗。糖皮质激素单独用药效果不佳,可作为辅助用药与免疫抑制剂合用,可改善患者B症状和血细胞减少,用量为泼尼松每日1 mg/kg,口服1个月后逐渐减量[5]。本例患者采用CsA+MTX方案治疗中,出现肾功能损害等不良反应,及时调整方案为CTX+MTX,并降低CsA用量,配合小剂量泼尼松治疗,取得很好的疗效。
GBS即急性炎症性脱髓鞘性多发性神经病或急性炎性脱髓鞘性多发性神经根神经炎,是引起四肢急性对称迟缓性瘫痪的最常见致病因素之一[6]。临床特征为急性起病,临床症状多在2周左右达到高峰,表现为多发神经根及周围神经损害,常有脑脊液蛋白-细胞分离现象,多呈单时相自限性病程[7]。
针对GBS的一般治疗主要对患者的心肺功能进行监护和治疗。针对性治疗GBS的治疗目前主要包括血浆置换、免疫球蛋白疗法等,早期应用是非常有益及必要的,尤其对处在进展期的患者[8]。静脉用免疫球蛋白每日400 mg/kg,连用3~5 d,以后每周1次,连用2~4周,直到临床恢复到一定程度为止。大规模实验证明静脉免疫球蛋白(IVIG)治疗疗效肯定,病情反跳和抗体反跳发生率低,可缩短病程,为治疗所首选[9]。
约74%的LGLL患者合并自身免疫紊乱[10],我国以纯红细胞AA多见,西方国家以类风湿关节炎多见,干燥综合征、系统性红斑狼疮亦有报道。目前尚鲜见T-LGLL合并GBS的报道。Bareau等[10]在对201例T-LGLL患者的研究中,发现3例合并多发性神经炎患者。GBS发病机制及发病环节中具体的免疫作用原理仍不明确。免疫系统肿瘤可能导致GBS,与细菌感染致病类似。在淋巴细胞增生性疾病中,外周神经免疫损伤易感性增加,恶性肿瘤作为一种抗原因素,也可刺激机体针对神经系统发生免疫作用,尤其是一些发生于免疫系统的恶性肿瘤如淋巴瘤等,易导致GBS[9]。有文献报道,GBS患者发病时体内辅助性T细胞(Th细胞)功能亢进,抑制性T细胞(Ts细胞)功能降低,T淋巴细胞过度激活可以诱导B细胞产生针对周围神经髓鞘的抗体,并激活补体系统,产生膜攻击复合物(C5b-9),从而导致周围神经髓鞘变性,而活化的T淋巴细胞又可对周围神经的髓鞘和施旺氏细胞产生直接毒害作用[2],T-LGLL中存在因CTL恶性增殖而导致的B细胞功能的调节异常[11],从而导致GBS的发生。T-LGLL合并GBS可能原因与化疗后免疫抑制有关,易并发感染。多数GBS发病前有病毒和细菌感染史,约2/3的成年患者在神经症状开始前的4周内有呼吸道或者肠道感染,发病前感染因子引起的分子模拟效应是GBS发生的一个重要原因[2]。本例患者在发病前有肠道和肺部的前驱感染。由于前驱感染病原体与机体周围神经髓鞘中的某些成分有相同或相似的抗原决定表位,感染病原体后机体免疫系统不能正确识别自体和异体抗原,错误识别,产生自身免疫性T淋巴细胞和自身抗体,并对自体周围神经和脊神经组分发生交叉免疫反应,引起周围神经和脊神经髓鞘脱失,严重者可继发轴索变性[8],另外感染可诱导抗原特异性T细胞和B细胞克隆活化,引发Schwann细胞的局部炎症和中毒反应从而致病[12]。
综上所述,T-LGLL合并GBS罕见,具体发病机制可能与T-LGLL疾病本身的淋巴细胞功能紊乱以及化疗后免疫抑制合并感染相关。治疗上除了对原发病及感染的控制外,针对GBS的IVIG等治疗也非常必要。
所有作者均声明不存在利益冲突